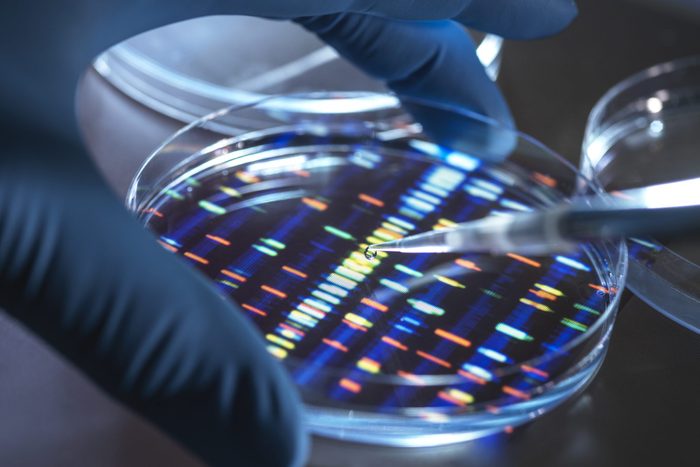
Scientist pipetting sample into tray for DNA testing in laboratory

We unpack the latest research on the possible hidden risks of artificial sweeteners.
5 Risks of Artificial Sweetener, According to Research

The dilemma of artificial sweeteners continues to stir conversations: Are they a safe sugar alternative or a hidden threat to health? As many diligently seek to minimize sugar consumption, enjoying sweet flavors without the accompanying calories is undoubtedly alluring. Recent studies suggest that this seemingly innocent delight might have unexpected consequences.

1. Memory and learning deficits
A study from the Florida State University (FSU) College of Medicine has found a connection between aspartame, a widely used artificial sweetener, and learning and memory deficits, specifically in mice. Co-author Pradeep Bhide, PhD, Chair of Developmental Neuroscience at FSU, indicated that the impacts of aspartame are notably more extensive than his previous research suggested. The findings, published in the peer-reviewed journal Scientific Reports in August 2023, revealed that the offspring of male mice consuming aspartame showed spatial learning and memory deficits during a controlled 16-week exposure period. Dr. Bhide highlighted that while they can function, they may require additional time or assistance, pointing towards the importance of examining the multi-generational effects of aspartame.

2. Mental health implications
A September 2023 study co-authored by Harvard T.H. Chan School of Public Health researchers found a link between ultra-processed foods, especially those containing artificial sweeteners, and an increased risk of developing depression. Andrew Chan, MD, MPH, a Department of Immunology and Infectious Diseases professor at Harvard noted that people “may wish to limit their intake of ultra-processed foods wherever possible”—particularly those already living with depression or other mental health conditions. The study found that participants consuming the most ultra-processed foods had a 50% higher risk of developing depression than those consuming the least.
Eating This Every Day Could Damage Your Brain Health, Says New Study

3. The gut microbiome
The consumption of artificial sweeteners, such as saccharin, sucralose and stevia, has been linked to alterations in the gut microbiome, as per a 2019 scientific review published in the peer-reviewed journal Advances in Nutrition. The review emphasizes a nuanced perspective, acknowledging the general safety of nonnutritive sweeteners and low-calorie sweeteners but also highlighting ongoing debates regarding their impacts on human health, particularly the gut microbiome. Some sweeteners, including certain polyols, have even been associated with increased beneficial bifidobacteria in the gut.
3 Worst Foods That Cause an Unhealthy Gut, from a Seattle Gastroenterologist

4. Weight control controversy
While non-sugar sweeteners (NSS) are often promoted as aids for weight loss, the World Health Organization (WHO) suggests caution. Francesco Branca, MD, PhD, WHO’s Director for Nutrition and Food Safety, emphasizes that substituting free sugars with NSS doesn’t benefit long-term weight control. Instead, he recommends alternatives like naturally sweet foods such as fruits, or opting for unsweetened food and beverages. This stance stems from research indicating that NSS might not provide lasting advantages in body fat reduction and could even pose risks, including heightened chances of type 2 diabetes, cardiovascular diseases, and increased mortality in adults. It’s worth noting that WHO’s recommendation is general but excludes individuals with pre-existing diabetes.
What Is Your ‘Set Point Weight’? How To Gauge It—And Why a Doctor Says You Should
5. Genotoxicity and potential carcinogenicity
New research has raised concerns about the safety of popular artificial sweeteners sucralose and aspartame due to their potential genotoxic and carcinogenic effects. A May 2023 study from researchers at NC State University found that sucralose could permanently damage DNA and exceed recommended toxicological thresholds. Assessments of aspartame by organizations like the WHO and IARC have also spotlighted potential carcinogenic properties, despite its general safety at common usage levels. Dr. Branca emphasized the need for “more and better studies” to investigate the described potential effects of aspartame.

The need for further research
While artificial sweeteners continue to be a popular alternative to sugar, it’s crucial to approach them with caution and awareness of the potential risks involved. Balancing your diet with natural sweetness from fruits and mindful sugar consumption might just be the key to savoring the sweet moments without compromising your health.
Clearly, this situation highlights an urgent need for more in-depth research into the extensive effects of these sweeteners.
For wellness updates delivered daily, subscribe to The Healthy @Reader’s Digest newsletter and follow The Healthy on Facebook and Instagram. Keep reading:




















